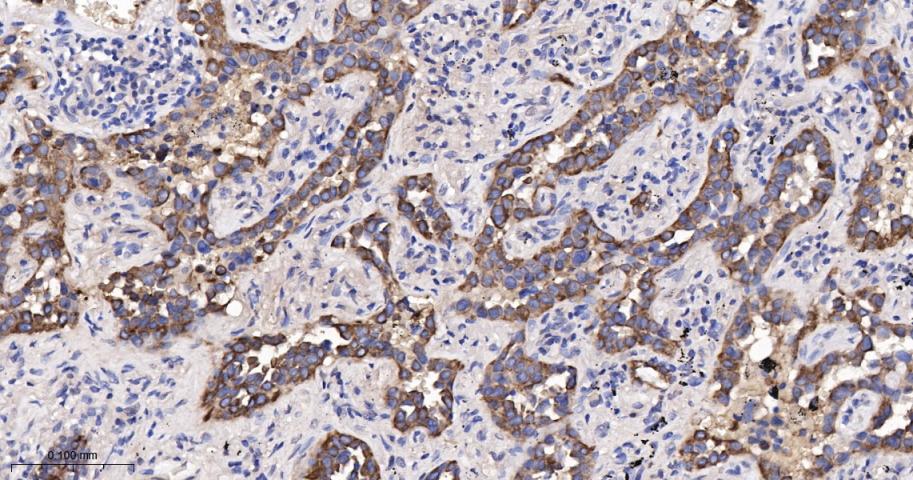
细胞角蛋白18单克隆抗体-bsm-33103M
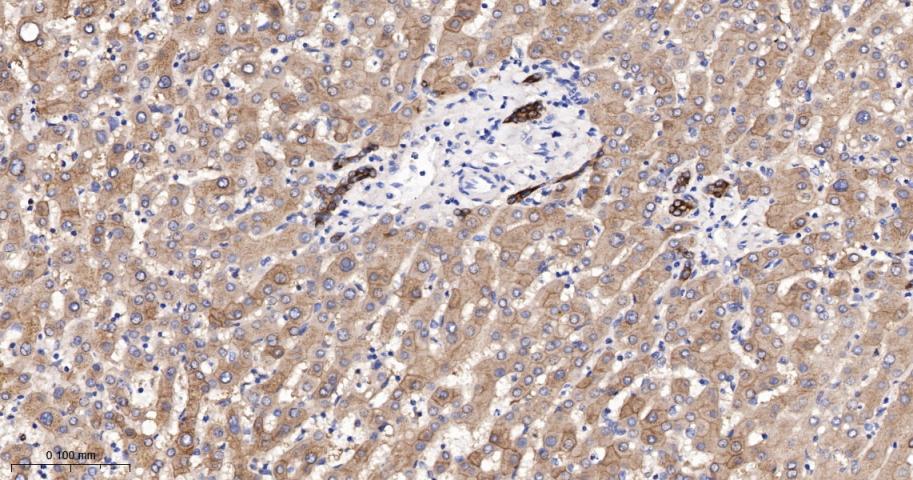
细胞角蛋白18单克隆抗体-bsm-33103M

CK18 Mouse mAb (一抗) - WB,IHC-P,IHC-F,IF,Flow-Cyt,ICC/IF | Bioss

货号:bsm-33103M
产品详情
相关标记
相关产品
相关文献
常见问题
概述
产品编号
bsm-33103M
产品类型
病理级抗体
英文名称
CK18 Mouse mAb
中文名称
细胞角蛋白18单克隆抗体
英文别名
CK-18; CYK18; K18; CK18; Krt1-18; K1C18_HUMAN; KRT18; Cell proliferation-inducing gene 46 protein; Cytokeratin-18 (CK-18); Keratin-18 (K18); K1C18_MOUSE; Cytokeratin endo B (Keratin D); Kerd; K1C18_RAT; keratin 18; keratin 18, type I
抗体来源
Mouse
免疫原
Recombinant human CK18 protein
亚型
IgG
性状
Size : 50ul/100ul/200ul
Liquid
Size : 200ug (PBS only)
Lyophilized
Note: Centrifuge tubes before opening. Reconstitute the lyophilized product in distilled water. Optimal concentration should be determined by the end user.
Liquid
Size : 200ug (PBS only)
Lyophilized
Note: Centrifuge tubes before opening. Reconstitute the lyophilized product in distilled water. Optimal concentration should be determined by the end user.
纯化方法
affinity purified by Protein G
克隆类型
Monoclonal
克隆号
10H2
理论分子量
48 kDa
检测分子量
47 kDa
浓度
1mg/ml
储存液
Size : 50ul/100ul/200ul
0.01M TBS (pH7.4) with 1% BSA, 0.02% Proclin300 and 50% Glycerol.
Size : 200ug (PBS only)
0.01M PBS
0.01M TBS (pH7.4) with 1% BSA, 0.02% Proclin300 and 50% Glycerol.
Size : 200ug (PBS only)
0.01M PBS
研究领域
SWISS
Gene ID
保存条件
Shipped at 4℃. Store at -20℃ for one year. Avoid repeated freeze/thaw cycles.
注意事项
This product as supplied is intended for research use only, not for use in human, therapeutic or diagnostic applications.
数据库链接
产品介绍
结构蛋白(Structural Proteins)常用于肿瘤细胞的分化、增殖及转移方面的研究。
背景资料
KRT18 encodes the type I intermediate filament chain keratin 18. Keratin 18, together with its filament partner keratin 8, are perhaps the most commonly found members of the intermediate filament gene family. They are expressed in single layer epithelial tissues of the body. Mutations in this gene have been linked to cryptogenic cirrhosis. Two transcript variants encoding the same protein have been found for this gene. [provided by RefSeq, Jul 2008]

产品应用
| 应用 | 已检合格种属 | 预测种属 | 推荐稀释比例 |
|---|---|---|---|
| WB | Human | 1:500-2000 | |
| IHC-P | Human | 1:200-1000 | |
| IHC-F | Human | 1:200-1000 | |
| IF | Human | 1:200-1000 | |
| Flow-Cyt | Human | 1ug/Test | |
| ICC/IF | Human | 1:100-500 |
交叉反应
交叉反应: Human
相关产品
暂无相关产品
靶标
基因名
KRT18
蛋白名
Keratin, type I cytoskeletal 18
亚基
Heterotetramer of two type I and two type II keratins. KRT18 associates with KRT8. Interacts with the thrombin-antithrombin complex (By similarity). Interacts with PNN, HCV core protein and mutated CFTR. Interacts with YWHAE, YWHAH and YWHAZ only when phosphorylated. Interacts with DNAJB6, TCHP and TRADD.
亚细胞定位
Cytoplasm, perinuclear region. Nucleus, nucleolus.
组织特异性
Expressed in colon, placenta, liver and very weakly in exocervix. Increased expression observed in lymph nodes of breast carcinoma.
翻译后修饰
Phosphorylation at Ser-34 increases during mitosis. Hyperphosphorylated at Ser-53 in diseased cirrhosis liver. Phosphorylation increases by IL-6.
Proteolytically cleaved by caspases during epithelial cell apoptosis. Cleavage occurs at Asp-238 by either caspase-3, caspase-6 or caspase-7.
O-GlcNAcylation increases solubility, and decreases stability by inducing proteasomal degradation.
Proteolytically cleaved by caspases during epithelial cell apoptosis. Cleavage occurs at Asp-238 by either caspase-3, caspase-6 or caspase-7.
O-GlcNAcylation increases solubility, and decreases stability by inducing proteasomal degradation.
疾病
Defects in KRT18 are a cause of cirrhosis (CIRRH) [MIM:215600].
相似性
Belongs to the intermediate filament family.
功能
When phosphorylated, plays a role in filament reorganization. Involved in the delivery of mutated CFTR to the plasma membrane. Involved in the uptake of thrombin-antithrombin complexes by hepatic cells (By similarity). Together with KRT8, is involved in interleukin-6 (IL-6)-mediated barrier protection.
同靶标产品
相关文献
提示: 发表研究结果有使用 bsm-33103M 时请让我们知道,以便我们可以引用参考文章。作为回馈,资料提供者将获得我们送上的小礼品。
具体参考文献:bsm-33103M 被引用于3文献中